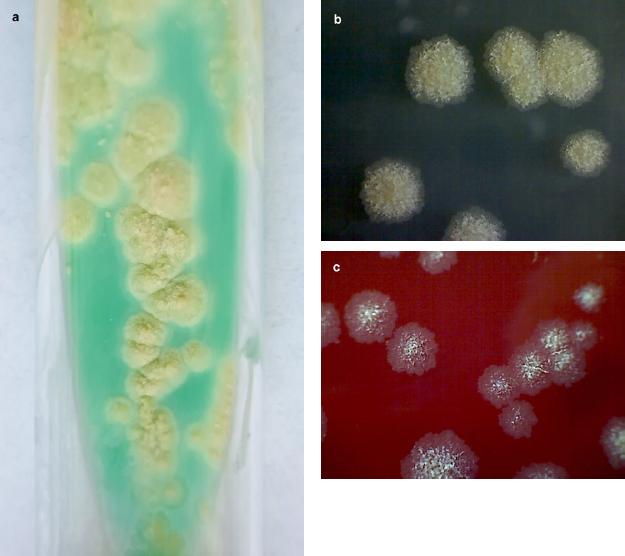

Over the past three decades, the incidence of infections caused by non-tuberculous mycobacteria (NTM) has increased. The prevalence of lung infections caused by NTM, representing approximately 200 species and subspecies, has increased dramatically over the last three decades, particularly among patients with cystic fibrosis (CF) (Floto et al. 2016; Abdelaal et al. 2022). NTM are facultative pathogenic microorganisms primarily responsible for opportunistic infections. They are widely distributed in the environment and can be found in diverse ecological niches, including water sources such as freshwater lakes, rivers, hot tubes, and soil. Moreover, NTM can form biofilms, facilitating their spread and colonization within the environment and among patients. Infections caused by NTM are primarily acquired through environmental exposure, although person-to-person transmission has been reported in some instances. NTM infections can affect lungs, skin and soft tissues, lymph nodes, joints, and bones, and disseminated infections can occur. Symptoms of NTM infections can range from mild to severe, and the clinical presentation often depends on a host’s immune status. Patient populations at a higher risk of NTM infections are individuals with cystic fibrosis, bronchiectasis, emphysema, chronic obstructive pulmonary disease, and immunocompromised conditions (Jang et al. 2014; Qvist et al. 2014; Kalaiarasan et al. 2020).
One of the most clinically relevant among rapidly growing mycobacteria (RGM) and very common among patients with CF are bacteria belonging to Mycobacterium abscessus complex (MABC) (Qvist et al. 2015; Stout et al. 2016; Schiff et al. 2019). Recently, the Mycobacterium genus has been split into five distinct genera (Mycolicibacterium, Mycolicibacter, Mycolicibacillus, Mycobacteroides, and an emended Mycobacterium). However, this species group comprises numerous significant obligate and opportunistic pathogens, so it is crucial to ensure that any changes in species nomenclature are apparent in clinical treatment. Thus, for the purpose of maintaining the clarity of meaning in clinical practice, the original designation of Mycobacterium, prior to the division of the genus into five genera, will be employed in this publication (www.bacterio.net/ mycobacterium.html; Meehan et al. 2021).
MABC is responsible for about 90% of respiratory tract disorders caused by RGM. Moreover, the mortality in patients with CF is very high. Other infections concern the skin, soft tissue, bone, and central nervous system (Medjahed et al. 2010; Cho et al. 2013; Abdalla et al. 2015). Furthermore, M. abscessus is also considered to be a high-risk factor for transplant failure (Kavaliunaite et al. 2020; Leard et al. 2021).
MABC showed resistance to the majority of routinely used antituberculosis drugs listed by the World Health Organization (WHO), and macrolides and amikacin remain the main therapeutic options. Most MABC infections are challenging to treat due to the numerous resistance mechanisms (Boeck et al. 2022; Li et al. 2022). Resistance to macrolides (clarithromycin, azithromycin) and aminoglycosides (kanamycin, amikacin, gentamicin) are associated with point mutations. While acquired macrolide resistance is associated with point mutations in a region of the rrl gene encoding the 23S rRNA, the inducible resistance is conferred by the erm(41) gene mutations. Long-term use of macrolides for the treatment of M. abscessus complex infection may, in consequence, lead to a decrease in their effectiveness throughout therapy (Bastian et al. 2011; Mase et al. 2020).
Resistance to aminoglycosides (kanamycin, amikacin, gentamicin) is the result of point mutations in the rrs gene (encoding 16S rRNA) or preventing the binding to a ribosomal target site by acyl or phosphate groups to aminoglycosides (Nessar et al. 2011; Broncano-Lavado et al. 2022). M. abscessus can grow in two different colony morphotypes, smooth (S) and rough (R), which are dependent on the presence or absence of surface-exposed glycopeptidolipids (GPL). Morphotypes (S) expresses GPL, while (R) variant demonstrates the lack of GPL. Those morphotypes are linked to different clinical manifestations (Bernut et al. 2016; Roux et al. 2016) (S) variant is capable of forming biofilms, whereas (R) variant lacks this ability. The process of alveoli colonization with M. abscessus begins with the (S) strains, which produce glycopeptidolipids and form a biofilm (Medjahed and Reyrat. 2009). On the other hand, in cases of invasive infection, mutations occurring in the (R) strains result in the production of trehalose dimycolate. This leads to the formation of cord-like structures and contributes to the virulence of these particular strains (Degiacomi et al. 2019). Morphotype (R) can persist within an infected host for prolonged periods. It is correlated with a significant decline in lung function by necrotic granuloma formation; moreover, it reveals decreased susceptibility to antibiotics (Kam et al. 2022).
Currently, the M. abscessus complex consists of 3 subspecies: M. abscessus subsp. abscessus, M. abscessus subsp. bolletii and M. abscessus subsp. massiliense (Choo et al. 2014). The need for an accurate species identification should be emphasized because of their different susceptibility patterns. M. abscessus subsp. massiliense has a nonfunctional erm(41) gene, leading to macrolide sensitivity and a favorable outcome for infection treatment (Koh et al. 2011; Harada et al. 2013; Roux et al. 2015).
The aim of the study was the evaluation of a rapid and effective assay to detect and discriminate species among NTM as well as among MABC and their mechanisms of resistance. Local monitoring of the prevalence of non-tuberculosis mycobacteria and their resistance profile enables proper antibiotic administration and ensures successful eradication therapy. Rapid detection of an etiological factor and molecular resistance profiles shortens the waiting time for results of microbiological designation. Thus, there is an urgent need to evaluate the performance of a new molecular assay for the rapid detection of clarithromycin and aminoglycoside resistance in the main clinically encountered NTM, including M. abscessus (subsp. abscessus, bolletii, and massiliense).
The study covered 223 NTM clinical strains from patients diagnosed in the Malopolska Central Laboratory of Tuberculosis Diagnostics, The Saint John Paul II Specialist Hospital, in Cracow, Poland. Isolates were collected between June 2018 and December 2021. Strains were isolated from the materials collected from the lower respiratory tract, such as samples from bronchial lavage (137/223) and sputum (62/223), extrapulmonary materials were minor: (13/223) lung tumor section (8/223), fragment of lymph nodes (2/223), peritoneal fluid (1/223), one from gastric lavage and one from a wound swab. According to the Infectious Disease Society of America recommendations, all strains were isolated from patients with confirmed mycobacteriosis (Daley et al. 2020).
The respiratory samples were decontaminated with 4% sodium hydroxide and 2,9% N-acetyl-L-cysteine (NaOH-NALC) (Merck KGaA, Germany). The samples were cultured on solid Löwenstein-Jensen medium (LJ) (Becton, Dickinson and Company, USA) and BBL MGIT tube using the automatic mycobacterial detection system BACTEC™ MGIT™ supplemented with OADC (Becton, Dickinson and Company, USA). All specimens were processed for acid-fast-bacilli (AFB) smear microscopy and culture on the collection day. Smears were screened by Auramine-O fluorescence microscopy under 400 × magnification (Fig. 1). Positive smears were re-examined with Ziehl-Neelsen staining to identify AFB under oil immersion (1,000 × magnification) (Fig. 2).

Mycobacterium abscessus subsp. abscessus. Photography of an auramine-stained acid-fast bacilli smear from liquid BBL culture. The visible bacilli forming cord-like structures.

Mycobacterium abscessus subsp. abscessus. Photography of smear stained by Ziehl-Neelsen method for acid-fast bacilli (AFB). Counterstaining creates a compelling visual contrast of red acid-fast bacilli.
All strains of M. abscessus were soaked on selective media for mycobacteria Löwenstein-Jensen and selective agar plates intended for the isolation of non-tuberculous mycobacteria (NTM Elite agar; bioMérieux, France) as well as non-selective media (i.e., Tryptic Soy Agar, Merck KGaA, Germany; and Columbia agar with 5% sheep blood, bioMérieux, France) (Fig. 3 and 4). All non-tuberculosis mycobacteria strains were pre-differentiated based on Runyon’s classification of non-tuberculous mycobacteria founded on the growth rate, yellow pigment production, and condition of pigment production – in the dark or only after exposure to light. Runyon groups one to three are slow-growing mycobacteria:
- –
Group I, photochromogenic mycobacteria – producing pigment after exposition to light,
- –
Group II, scotochromogenic mycobacteria – producing tint regardless of access to or a lack of light,
- –
Group III, nonchromogenic organisms – do not produce color under any conditions,
- –
Group IV, organisms are rapidly growing mycobacteria (5–7 days) that do not produce pigment.
Growth of Mycobacterium abscessus after 7 days of incubation at 37°C in aerobic condition.
a) cream-colored, waxy colonies on Löwenstein-Jensen medium
b) mycobacterial colonies on non-selective media – Tryptic Soy Agar
c) mycobacterial colonies on Columbia agar with 5% of sheep blood.

Culture of rapidly growing non-tuberculous mycobacteria on selective NTM Elite agar (bioMérieux, France), after 5 days of incubation at 37°C under aerobic conditions.
a) colonies of Mycobacterium fortuitum subsp. fortuitum ATCC® 6841™, b) rough colonies of Mycobacterium abscessus subsp. abscessus.
International standard rapid growth mycobacteria species were used as the corresponding quality control strains for the clinical isolates tested: Mycobacterium fortuitum subsp. fortuitum ATCC® 6841™, Mycobacterium peregrinum ATCC® 700686™, Mycobacterium tuberculosis subsp. tuberculosis ATCC® 27294™ as routine organisms in routine quality control (QC). As supplemental QC Staphylococcus aureus subsp. aureus ATCC® 29213™, Pseudomonas aeruginosa ATCC® 27853™ and/or Enterococcus faecalis ATCC® 29212™ were used.
At first, a bacterial colony was suspended in 150 ml of Vircell sample solution and incubated at 95°C for 60 min, according to the manufacturer’s recommendation. The supernatant, including extracted DNA, was used for further PCR analyses. Identification of 223 NTM strains was performed, using a Speed-Oligo® MYCOBACTERIA kit (Vircell Microbiologists, Spain) based on the amplification of a fragment of mycobacterial genomes and enabling for identification of Mycobacterium complex and thirteen most frequently isolated NTM species (M. abscessus complex, M. marinum/M. ulcerans, M. kansasii, M. xenopi, M. intracellulare, M. avium, M. scrofulaceum, M. malmoense, M. gordonae, M. interjectum, M. chelonae, M. fortuitum and M. peregrinum). Master Mix of a final volume 25 μl was prepared by adding 15 μl of the PCR mixture (supplied in the kit) and 10 μl of a DNA sample. The PCR assay was conducted with the following thermal profile: initial denaturation of 92°C for 60 s, and then 40 cycles of 92°C for 20 s, 55°C for 30 s, 72°C for 30 s, and final elongation of 72°C for 60 s. The PCR products were denatured by heating them at 95°C for 60 s and cooling on the ice. Then, 10 μl of the denatured PCR product was added to 35 μl of the hybridization solution (included in the kit) and heated to 55°C. Based on hybridization and alkaline phosphatase reaction on a membrane strip, specific strips were analyzed after incubation at 55°C for 10 minutes. The species identification was confirmed by comparing the absence or presence of specific strips for each tested sample with the reference bands. Each time during the identification, a negative control (deionized water) and a positive control of M. tuberculosis subsp. tuberculosis ATCC® 27294™ were performed. Isolates assigned to the M. abscessus complex were used for further research.
Total DNA was extracted using GenoLyse® VER. 2.0 (Hain Lifescience GmbH, Germany). Genomic DNA was extracted from a pure mycobacterial culture grown on Löwenstein-Jensen’s solid medium (Becton, Dickinson and Company, USA). The strains identified as M. abscessus were tested using GenoType CMdirect VER. 1.0 (Hain Lifescience GmbH, Germany). This assay enables a qualitative in vitro test for the identification of the M. tuberculosis complex as well as the following NTM from clinical specimens: M. avium, M. chelonae, M. abscessus complex, M. fortuitum group, M. gordonae, M. intracellulare, M. scrofulaceum/M. intracellulare, M. szulgai, M. interjectum, M. kansasii, M. malmoense, M. marinum/M. ulcerans, and M. xenopi. All tests detected DNA via hybridization and alkaline phosphatase reaction on a membrane strip. GenoLyse® kit (Hain Lifescience GmbH, Germany) was used for DNA extraction. All reagents needed for amplification, such as polymerase and primers, are included in the amplification mixes A and B (AM-A and AM-B). Amplification profile: initial denaturation of one cycle 95°C for 15 min, and then 20 cycles of 95°C for 30 s and 65°C for 120 s, 30 cycles 95°C for 25 s, 50°C for 40 s 70°C for 30 s and final elongation of 70°C for 8 min. GenoType NTM-DR molecular distinction within the complex of M. abscessus was performed according to the GenoType NTM-DR VER. 1.0 test procedure (Hain Lifescience GmbH, Germany) (GenoType NTM-DR 2015), according to the manufacturer’s recommendations. PCR was conducted using primers and thermal profiles as described by the manufacturer (Table I). The master mix of final volume 50 μl contained 10 μl AM-A and 35 μl AM-B reagents (included in the kit) and 5 μl of extracted DNA. The PCR assay was conducted with the following cycle profile: initial denaturation at 95°C for 15 min, followed by 10 cycles at 95°C for 30 s, 65°C for 120 s, and then 20 cycles of 95°C for 25 s and 50°C for 40 s and 70°C for 40 s and a final extension at 70°C for 8 min.
Interpretation of susceptibility pattern of rapidly growing mycobacteria according to the CLSI recommendations.
| Antimycobacterial agents | MIC breakpoints (μg/ml) | ||
|---|---|---|---|
| S | I | R | |
| Amikacin | ≤ 16 | 32 | ≥ 64 |
| Cefoxitin | ≤ 16 | 32-64 | ≥ 128 |
| Doxycycline | ≤ 1 | 2-4 | ≥ 32 |
| Ciprofloxacin | ≤ 1 | 2 | ≥ 4 |
| Clarithromycin | ≤ 2 | 4 | ≥ 8 |
| Linezolid | ≤ 8 | 16 | ≥ 32 |
| Moxifloxacin | ≤ 1 | 2 | ≥ 4 |
| Trimthoprim/sulfamethoazole | ≤ 2/38 | – | ≥ 4/76 |
| Imipenem | ≤ 4 | 8-16 | ≥ 32 |
| Tigecycline* | – | – | – |
S – susceptible, I – intermediate, R – resistant
* – insufficient data on tigecycline’s correlation between in vitro results and clinical response hinders the establishment of breakpoints to differentiate susceptible from resistant strain, thus only MIC should be reported
MALDI-TOF MS (Matrix-assisted laser desorption ionization-time of flight mass spectrometry) identification of the selected strains of NTM was performed using the MALDI Biotyper® sirius IVD System (Bruker Daltonics, France). The protein extraction procedure for analysis was carried out under the manufacturer’s recommendations. Mycobacteria extraction MycoEX method was conducted according to standard operating procedure. All samples were prepared from solidmedium. Firstly, three 10 μl loops of mycobacterial biomass were transferred into 300 μl of deionized water in Eppendorf tubes and inactivated at 95°C by boiling them for 30 min. 900 μl EtOH was pipetted into an Eppendorf tube and centrifuged for 2 minutes at maximum speed. Then, the supernatant was discarded. The pellet was left at room temperature to dry. Silica beads were added to the Eppendorf tubes to thoroughly break up the mycobacterial colonies, followed by adding 20 μl of pure acetonitrile and vortexed at full speed for 1 minute. A 20 μl volume of 70% formic acid was added, vortexed, and then centrifuged at maximum speed for 2 min. Finally, 1 μl of the supernatant was placed on the MALDI-TOF target plate and allowed to dry at room temperature. Immediately after the sample spot had dried, the spot was overlaid with 1 μl of HCCA matrix. The species identification was conducted using Bruker software to compare the protein profile of the bacteria obtained from a database of protein profiles. The MBT Mycobacteria RUO Library 7.0 covers 182 of 201 mycobacteria species. A range 1.8–3.0 indicates a high-confidence identification of genus and species. A score > 1.7 indicates the identification of genus but not species, and a score lower than 1.7 indicates no identification of bacteria.
Minimum inhibitory concentrations (MICs) of clarithromycin (PHR1038; Merck KGaA, Germany) and amikacin (PHR1654; Merck KGaA, Germany) were determined by the broth microdilution method according to CLSI recommendation (CLSI 2018a) and ISO norm (ISO 20776-1:2019 2019).
The analysis of 11 strains M. abscessus complex was performed (one strain failed to pass for further culture). Briefly, the assay was conducted with a pure bacterial culture. Single colonies of the same morphology were picked with a loop and transferred to 4.5 ml of sterile distilled water containing 7–10 sterile glass beads (3 mm). 50 μl suspension with a density of 0.5 McFarland was transferred to 10 ml of cation-adjusted Mueller-Hinton broth (CAMHB). 100 μl was distributed into each of the 96 well panels containing 100 μl of drug suspension. First, 200 μl of pure CAMHB broth was dispensed into all wells in column 1, then 200 μl of strain suspension was added to all wells in column 2, then 100 μl of pure CAMHB broth was poured into all wells of columns 3–12. Finally, 100 μl of the prepared antibiotic solution (1,024 μg/ml amikacin solution or 128 μg/ml clarithromycin solution) was poured into the wells of column 3. Then, two-fold dilutions were made by transferring 100 μl of the drug suspension from column 3 to the wells of the next column; this process was performed in the same way in the subsequent columns. The final volume in each row was 200 μl. The concentration ranges for amikacin were 0,5–128 μg/ml and 0.06–32 μg/ml. The 96-well microplate was sealed in a plastic bag and incubated at 30 ± 2°C for 3–5 days (depending on the growth in the control well). After incubation, plates were read according to the CLSI guidelines (Appendix 4.3.2.3). The interpretation of the result was based on CLSI recommendation (Table I) (CLSI 2018a; 2018b).
Simultaneously, a commercially available Sensititre™ RAPMYCO2 Susceptibility Testing Plate (Thermo Fisher Scientific, Inc., USA) was used to evaluate MIC by the broth microdilution method. The broth microdilution method provided by Sensititre™ RAPMYCO2 was a validated method for the susceptibility testing of RGM including M. fortuitum group, M. chelonae, M. abscessus group, M. mucogenicum, and M. smegmatis group, Nocardia spp., and other aerobic actinomycetes. A 96-well microplate panel included 16 anti-mycobacterial drugs: amikacin (1–64 μg/ml), cefoxitin (4–128 μg/ml), ciprofloxacin (0.12–4 μg/ml), clarithromycin (0.06–16 μg/ml), doxycycline (0.12–16 μg/ml), imipenem (2–64 μg/ml), linezolid (1–32 μg/ml), minocycline (1–8 μg/ml), moxifloxacin (0.25–8 μg/ml), tigecycline (0.015–4 μg/ml) trimethoprim/sulfamethoxazole (0.25/4.75 – 8/152 μg/ml) and cefepime (1–32 μg/ ml), amoxicillin/clavulanic acid 2:1 ratio (2/1–64/32), ceftriaxone (4–64 μg/ml), minocycline (1–8 μg/ml), tobramycin (1–16 μg/ml). MIC values of all tested anti-mycobacterial drugs were read between 3 to 5 days of incubation if control growth was positive. The incubation was extended to 14 days for clarithromycin to detect induced macrolide resistance. Susceptibility and resistance were assessed according to the CLSI recommendations (CLSI 2018a; 2018b).
Molecular evaluation of susceptibility to aminoglycosides and macrolides was determined by GenoType NTM-DR VER. 1.0 that enables the detection of point mutations referring to resistance to these classes of drugs. The analysis was conducted as described above. Based on hybridization and alkaline phosphatase reaction on a membrane strip, specific strips allow for the determination of the resistance mechanisms (Table II). Wild strains without macrolides resistance mechanisms reveal rrl WT band, while without aminoglycosides resistance – rrs WT band.
Interpretation of the mutation type conferring to the macrolides and aminoglicosides resistance according to the GenoType NTM-DR VER 1.0 test instructions.
| Discernible phenotypic pattern resistance | Target nucleic acid sequence | Nascent mutation band | Mutation |
|---|---|---|---|
| Macrolides | 2058–2059 | rrl MUT1 | A2058C |
| rrl MUT2 | A2058G | ||
| – | A2058T | ||
| rrl MUT3 | A2059C | ||
| rrl MUT4 | A2059T | ||
| Aminoglycosides | 1406–1409 | rrs MUT1 | A1408G |
| – | T1406A | ||
| – | C1409T |
Based on phenotypic and molecular assays, as well as the MALDI-TOF analysis, the species identification was conducted. In total, 223 NTM strains were isolated from patients between 2018–2021. Among them, 35% (77/223) were M. kansasii, 27% (61/223) M. avium, both of M. intracellulare and M. xenopi were 14% (31/223), M. abscessus 5,4% (12/223), the remaining RGM strains (M. fortuitum, M. gordonae, M. malmoense, M. chelonae) were in total 3,1% (7/223).
The analysis of the frequency of NTM occurrence over the years revealed 66 strains in 2018, 48 in 2019, 39 in 2020, and 70 in 2021. Within isolated strains, the most frequent was M. kansasii every year. At the same time, the species with the lowest prevalence rate were M. gordonae and M. chelonae with a single case in three years (Fig. 5).

Prevalence of non-tuberculosis mycobacteria species isolated from patients in the Malopolska region of Poland, etween 2018–2022. Each year, the most prevalent species were Mycobacterium kansasii and Mycobacterium avium. Occurrence of Mycobacterium abscessus varies between the years and amounted to three strains in 2018, one in 2020, and eight in 2021.
The initial phenotypic identification showed that among all 223 NTM strains, 19 belonged to the RGM group. Molecular discrimination (CM Direct) confirmed 12 isolates as M. abscessus. Subspecies were discriminated by a GenoType NTM DR test. The results revealed nine M. abscessus subsp. abscessus and three M. abscessus subsp. massiliense and one M. abscessus subsp. bolletii (Fig. 6). Speed-Oligo and CM Direct methods demonstrated concordance in species identification (100%). Phenotypic identification by MALDI-TOF analysis enables only the determination of species level, and the precise discrimination within the complex was only achievable using GenoType NTM DR.

Analysis of the banding patterns received for 12 clinical strains (strips 1–12) with the use of GenoType NTM DR (Hain Lifescience GmbH, Germany). The strips coated with specific probes are complementary to selectively amplified nucleic acid sequences, that enable species determination as well as point mutations referring to resistance to aminoglycosides and macrolides.
| Strip 1 | – a clinical strain of Mycobacterium abscessus subs. abscessus (band characteristic for M. abscessus subsp. abscessus; SP4, SP5, SP6, SP9, SP10); no point mutation was detected; |
| Strips 2-6, 10, 12 - | –clinical strains of M. abscessus subs. abscessus (band characteristic for M. abscessus subsp. abscessus; SP4, SP5, SP6, SP9, SP10); point mutation erm(41)T28 referring to macrolide resistance; |
| Strips 7, 9 | – clinical strains of M. abscessus subs. massiliense (band characteristic for M. abscessus subsp. massiliense; SP4, SP5, SP8, SP9); point mutation erm(41)T28 no clinical implication in case of M. masiliense; |
| Strips 8 | – clinical strains of M. abscessus subs. abscessus (band characteristic for M. abscessus subsp. abscessus; SP4, SP5, SP6, SP9, SP10); point mutations were detected: erm(41)T28 and rrl MUT referring to macrolide resistance as well as point mutation A1408G referring to amikacin resistance; |
| Strip 11 | – clinical strains of M. abscessus subs. bolletii (band characteristic for M. abscessus subsp. bolletii; SP4, SP5, SP6, SP7, SP9, SP10), point mutation erm(41)T28 referring to macrolide resistance. |
Antimicrobial susceptibility testing was performed for 11 M. abscessus strains (one strain failed to pass for further culture). Susceptibility testing was evaluated in two microdilution methods: commercially available test Sensititre™ RAPMYCO2 and manually prepared microdilution 96-well titrate plate. Sensititre™ RAPMYCO2 results are presented in Table III. All strains (11/11, 100%) of M. abscessus were resistant to ciprofloxacin, while most strains (10/11; 90,9%) reveal resistance to doxycycline and trimethoprim/sulfamethoxazole. Only one (9,1%) strain remains susceptible to doxycycline and one – reveals intermediate resistance to trimethoprim/sulfamethoxazole. A high resistance rate was demonstrated also in moxifloxacin – 81,8% (9/11), while 18,2% (2/11) was intermediate. In the case of clarithromycin, 63,6% (7/11) isolates were resistant, and 36,4% (4/11) remained susceptible. The results obtained by Sensititre™ RAPMYCO2 and by manually performed susceptibility assay to clarithromycin were consistent (Table III and IV). Lower resistance rate M. abscessus presented for cefoxitin – 36,4% (4/11) resistant and 64,6% (7/11) – intermediate. Most isolates were susceptible to linezolid (64,6%, 7/11), and only 36,4% (4/11) were intermediate. The results of Sensititre™ RAPMYCO2 revealed that all strains were susceptible to amikacin. MIC values ranged from 4–16 μg/ml. Manually conducted microdilution assay confirms these results (Table III and IV, Fig. 7). In the case of tigecycline, there is insufficient data on its correlation between in vitro results of susceptibility testing and clinical response. Based on CLSI recommendations (CLSI 2018a; 2018b) only MIC should be reported, and the therapy with tigecycline depends on MIC values. Tested strains presented MIC ranged from 0,2 to 2 μg/ml.
Results of susceptibility testing to antimycobacterial agents obtained by Sensititre™ RAPMYCO2 plates. Interpretation criteria following CLSI.
| MIC values (μg/ml) (Interpretation S/I/R) | ||||||||||||
|---|---|---|---|---|---|---|---|---|---|---|---|---|
| No. | Species | AN | FOX | CIP | DOX | LZD | MXF | SXT | IMI | TGC | CLA after 5d | CLA after 14 d |
| 1 | Mabs | 16 (S) | 64 (I) | > 4 (R) | > 16 (R) | ≤ 1 (S) | 4 (R) | 4/76 (R) | 16 (I) | MIC = 1 | 0,06 (S) | 0,125 (S) |
| 2 | Mabs | 16 (S) | >128 (R) | > 4 (R) | > 16 (R) | 4 (S) | 2 (I) | > 8/152 (R) | 16 (I) | MIC = 0,5 | 0,06 (S) | > 16 (R) |
| 3 | Mabs | 16 (S) | 32 (I) | > 4 (R) | > 16 (R) | 4 (S) | > 8 (R) | 4/76 (R) | 16 (I) | MIC = 0,5 | 0,5 (S) | > 16 (R) |
| 4 | Mabs | 16 (S) | >128 (R) | > 4 (R) | > 16 (R) | 16 (I) | > 8 (R) | > 8/152 (R) | 16 (I) | MIC = 2 | 0,06 (S) | > 16 (R) |
| 5 | Mabs | 16 (S) | 64 (I) | > 4 (R) | > 16 (R) | 16 (I) | > 8 (R) | > 8/152 (R) | 16 (I) | MIC = 1 | 0,06 (S) | > 16 (R) |
| 6 | Mabs | 16 (S) | 64 (I) | > 4 (R) | > 16 (R) | 4 (S) | > 8 (R) | > 8/152 (R) | 16 (I) | MIC = 2 | 4 (I) | > 16 (R) |
| 7 | Mmas | - | - | - | - | - | - | - | - | - | - | - |
| 8 | Mmas | 16 (S) | >128 (R) | > 4 (R) | > 16 (R) | 16 (I) | 4 (R) | 4/76 (R) | 16 (I) | MIC = 0,25 | 0,06 (S) | 0,125 (S) |
| 9 | Mabs | 16 (S) | >128 (R) | > 4 (R) | > 16 (R) | 16 (I) | 4 (R) | 4/76 (R) | 16 (I) | MIC = 0,5 | 0,06 (S) | 0,125 (S) |
| 10 | Mmas | 16 (S) | 32 (I) | > 4 (R) | 1 (S) | 1 (S) | 2 (I) | 2/38 (S) | 16 (I) | MIC = 0,5 | 0,06 (S) | 0,06 (S) |
| 11 | Mbol | 4(S) | 32 (I) | > 4 (R) | > 16 (R) | 4 (S) | > 8 (R) | > 8/152 (R) | 16 (I) | MIC = 0.25 | 0.06 (S) | > 16 (R) |
| 12 | Mabs | 4 (S) | 33 (I) | > 4 (R) | > 16 (R) | 8 (S) | > 8 (R) | > 8/152 (R) | 16 (I) | MIC = 0.12 | 4 (I) | > 16 (R) |
Mabs – Mycobacterium abscessus subsp. abscessus, Mmas – Mycobacterium abscessus subsp. massiliense, Mbol – Mycobacterium abscessus subsp. bolletii S – susceptible, I – intermediate, R – resistant, AN – amikacin, FOX – cefoxitin, CIP – ciprofloxacin, DOX – doxycycline, LZD – linezolid, MXF – moxifloxacin, SXT – trimethoprim/sulfamethoxazole, IMI – imipenem, TGC – tigecycline, CLA – clarithromycin
Results of susceptibility testing to amikacin and clarithromycin obtained by manually conducted microdilution method. Interpretation criteria following CLSI.
| No. | Species | AN | Interpretation* | CLA after 5 days of incubation | Interpretation* | CLA after 14 days of incubation | Interpretation* |
|---|---|---|---|---|---|---|---|
| 1 | Mabs | 16 | (S) | 0.06 | (S) | 0,5 | (S) |
| 2 | Mabs | 8 | (S) | 0.06 | (S) | > 64 | (R) |
| 3 | Mabs | 16 | (S) | 0.06 | (S) | = 32 | (R) |
| 4 | Mabs | 16 | (S) | 0.06 | (S) | = 32 | (R) |
| 5 | Mabs | 16 | (S) | 0.06 | (S) | = 32 | (R) |
| 6 | Mabs | 16 | (S) | 0.06 | (S) | = 32 | (R) |
| 7 | Mmas | – | – | – | – | – | – |
| 8 | Mmas | 16 | (S) | 0.06 | (S) | = 0.125 | (S) |
| 9 | Mabs | 16 | (S) | 0.06 | (S) | = 0.125 | (S) |
| 10 | Mmas | 16 | (S) | 0.06 | (S) | = 0.06 | (S) |
| 11 | Mbol | 0.5 | (S) | 0.06 | (S) | > 64 | (R) |
| 12 | Mabs | 0.250 | (S) | 4 | (R) | = 16 | (R) |
Mabs – Mycobacterium abscessus subsp. Abscessus, Mmas – Mycobacterium abscessus subsp. massiliense, Mbol – Mycobacterium abscessus subsp. bolletii
S – susceptible, I – intermediate, R – resistant
AN – amikacin, CLA – clarithromycin
* – interpretation of the result was done according CLSI

MIC value of selected antimycobacterial agents obtained by RAPMYCO2 plate. AN – amikacin, CIP – ciprofloxacin, DOX – doxycycline, LZD – linezolid, MXF – moxifloxacin, TGC – tigecycline, CLA – clarithromycin, IMI – imipenem
Results of molecular identification of mechanisms of resistance reveal that only one strain exhibits point mutation in rrs gene referring to amikacin resistance. All the results obtained with the phenotypic method were in accordance with molecular identification, except for one strain. Strain no. 9 was classified as susceptible to amikacin by using the phenotypic method (MIC was 16 μg/ml), while the molecular assay presented the point mutation within rrs gene – the transition of adenine to guanin in position 4108 (Table V).
Results of molecular identification of resistance mechanisms to amikacin obtained by GenoType NTM in relation to phenotypic susceptibility testing results.
| No. of strain | Species | GenoType NTM-DR results | Phenotypic results of susceptibility to amikacin | |
|---|---|---|---|---|
| Type of bands (WT or mutation) | Molecular mechanisms of resistance (Yes/No) | |||
| 1 | Mabs | rrs rrs WT | No | (S) |
| 2 | Mabs | rrs rrs WT | No | (S) |
| 3 | Mabs | rrs rrs WT | No | (S) |
| 4 | Mabs | rrs rrs WT | No | (S) |
| 5 | Mabs | rrs rrs WT | No | (S) |
| 6 | Mabs | rrs rrs WT | No | (S) |
| 7 | Mmas | rrs rrs WT | No | nt |
| 8 | Mmas | rrs rrs WT | No | (S) |
| 9 | Mabs | rrs MUT1 (A1408G) | Yes | (S) |
| 10 | Mmas | rrs rrs WT | No | (S) |
| 11 | Mb ol | rrs rrs WT | No | (S) |
| 12 | Mabs | rrs rrs WT | No | (S) |
Mabs – Mycobacterium abscessus subsp. abscessus,
Mmas – Mycobacterium abscessus subsp. massiliense,
Mbol – Mycobacterium abscessus subsp. bolletii
S – susceptible, nt – not tested
A molecular assay to determine the resistance of M. abscessus to clarithromycin showed that nine strains presented point mutations in the erm and/ or rrl gene. Similarly, as in the case of amikacin resistance, the phenotypic and molecular identification of resistance remains in compliance, except for strain no. 9 (Table VI). Among M. abscessus subs. abscessus six strains revealed a mutation in the erm gene (T28) (strains no. 2–6, 12), one presented both in the erm and rrl genes simultaneously (strain no. 9), and one remains susceptible without point mutations (strain no. 1). All M. abscessus subs. massiliense were susceptible and did not pose mutation in the erm or rrl genes. However, due to the deletion in the erm(41) gene, M. abscessus subs. massiliense the gene is non-functional, leading to macrolide sensitivity regardless of the resulting erm(41)T28 band (strains no. 7, 8, 10). One isolate of M. abscessus subs. bolletii revealed point mutation in the erm gene (T28) (strain no. 11).
Results of molecular identification of resistance mechanisms to clarithromycin by GenoType NTM in relation to phenotypic susceptibility testing results.
| No. of strain | Species | GenoType NTM-DR results | Phenotypic results of susceptibility to clarithromycin | |
|---|---|---|---|---|
| Type of bands (WT or mutation) | Molecular mechanisms of resistance (Yes/No) | |||
| 1 | Mabs | erm(41) C28 rrlWT | No | (S) |
| 2 | Mabs | erm(41)T28 rrlWT | Yes | (R) |
| 3 | Mabs | erm(41)T28 rrlWT | Yes | (R) |
| 4 | Mabs | erm(41)T28 rrlWT | Yes | (R) |
| 5 | Mabs | erm(41)T28 rrlWT | Yes | (R) |
| 6 | Mmas | erm(41)T28 rrlWT | Yes | (R) |
| 7 | Mmas | erm(41)T28* rrlWT | No | nt |
| 8 | Mmas | erm(41)T28* rrlWT | No | (S) |
| 9 | Mabs | erm(41)T28 rrlMUT | Yes | (S) |
| 10 | Mb ol | erm(41)T28* rrlWT | No | (S) |
| 11 | Mabs | erm(41)T28 rrlWT | Yes | (R) |
| 12 | Mabs | erm(41)T28 rrlWT | Yes | (R) |
Mabs – Mycobacterium abscessus subsp. abscessus,
Mmas – Mycobacterium abscessus subsp. massiliense,
Mbol – Mycobacterium abscessus subsp. bolletii
S – susceptible, R – resistant, nt – not tested
* – due to the deletion in the erm(41) gene, M. abscessus subs. massiliense the gene is non-functional, leading to macrolide sensitivity regardless of the resulting erm(41) T28 band (except strains with the rrl mutation)
The prevalence of MABC and other mycobacteria species was investigated in our research conducted between 2018 and 2021. Notably, only strains isolated for the first time from clinically confirmed mycobacteriosis patients were included in the analysis. Consistent with the literature on the epidemiology of NTM in Europe (Wassilew et al. 2016), as well as the previous investigation in Poland (Hoefsloot et al. 2013), our study results demonstrated a predominant prevalence of the M. avium complex (MAC) each year. According to our findings, in 2018, the most prevalent mycobacteria belonged to MAC complex (44.9% of isolates), with M. avium accounting for 21.7%. The second most common species was M. kansasii, with an isolation frequency of 30%, while species belonging to M. abscessus complex accounted for 4.34% of isolates. Similarly, in 2019, the most frequent group, with the prevalence comparable to the data from 2018, remained M. avium complex. M. kansasii accounted for nearly a half of all isolates obtained (48%), while no MABC isolates were observed. In 2020, the frequency of M. kansasii isolation decreased significantly to 25.6%, while MAC strains accounted for 48.7% of isolation. Species from the MABC complex accounted for 2.56% of isolates. In 2021, the frequency of isolation of M. kansasii and mycobacteria from the M. avium complex was close to 35.3%, while for M. abscessus complex it increased more than four times compared to 2020 (11.8%) of strains. About the European data, among slow-growing mycobacteria (SGM), the most frequently isolated is MAC with an isolation frequency of 31% in Southern Europe and 44% in Northern Europe, respectively. Among this group, M. avium is the most frequently isolated strain (Nishiuchi et al. 2017). In Europe, the distribution of respiratory NTM isolates is as follows: MAC accounts for 37%, M. xenopi for 14%, M. kansasii for 5%, other slow-growing mycobacteria for 10%, M. gordonae for 12%, and rapid-growing mycobacteria (RGM) for 10%. While in Poland, the distribution is as follows: MAC constitutes 23%, M. kansasii 35%, M. xenopi 22%, RGM 14%, and M. gordonae 6% (Hoefsloot et al. 2013). The prevalence of MAC varied across different countries and amounted to 10% in Croatia, 20–23% in Poland, Slovakia, and Hungary, and ranged from 33% to 40% in countries such as the Netherlands, Greece, France, Belgium, Finland, Spain, Portugal, and Austria. The prevalence rate further increased to 55% in Germany and Norway, while Sweden exhibits the highest frequency of MAC isolation at 67%. (Hoefsloot et al. 2013). The prevalence of M. kansasii in Poland (and Slovakia) is reported to be three times higher compared to most other European countries. In these two countries, the frequency of infections caused by M. kansasii is approximately 33%, significantly higher than the prevalence rates ranging from 0% to 10% observed in most other European countries.
In our study, the average prevalence of slow-growing mycobacteria between 2018–2021 amounted to 91.93%, while bacteria belonging to rapid-growing mycobacteria were on average 8.07%. These data closely resembled those obtained within the NTM-NET collaborative study (Hoefsloot et al. 2013), 80% SGM and 20% RGM, respectively. The prevalence of NTM can vary across different regions and may be influenced by factors such as population demographics, geographic location, and diagnostic practices. In total, 5% of pulmonary infections are caused by rapidly growing mycobacteria, with approximately 65–80% of RGM infections specifically attributed to M. abscessus (Luo et al. 2016). The most common etiological agent of pulmonary disease caused by RGM is MAB, representing 3–13% of all NTM (Honda et al. 2018) M. abscessus has the potential to cause infections in various areas of the body, including lymph nodes, skin, soft tissues, bone joints cartilage and tendons and other pathological infections, in addition to pulmonary disease (Brown-Elliott and Wallace 2002). In cystic fibrosis patients it can lead to disseminated infections, especially after transplantations. It has also been associated with infection outbreaks in postsurgical wounds (Leao et al. 2009). In our study, we obtained the isolation frequency of all RGMs at the level of 8.07% in all four years of the study, while for M. abscessus the values were 4.43%, (2018), 2.56% (2020) and 11.8% in 2021. No M. abscessus strain were isolated in 2020. Among subspecies belonging to the MABC complex, M. abscessus subs. abscessus is the most common isolate, followed by M. abscessus massiliense and M. abscessus subsp. bolletii. However, the occurrence of the three subspecies may vary according to geographical distribution (Victoria et al. 2021). Our analysis remained in complete agreement with those data, M. abscessus subs. abscessus accounted for 66.7% of isolates, M. abscessus subs. massiliense for 25%, and M. abscessus subsp. bolletii for 8.3% of the isolates.
A notable finding is the complete absence of the MAB complex isolates in 2020. The decline in the number of isolates was undoubtedly attributed to the ongoing COVID-19 pandemic, which resulted in a reduced frequency of isolation and access to mycobacterial diagnostics. During this period, diagnostic efforts were primarily directed toward detecting COVID-19 cases, which may have led to a decline in identifying mycobacterial infections, including MABC, from pulmonary samples. Our results confirmed these assumptions. In 2018, the number of all cultures performed in the Malopolska Central Laboratory of Tuberculosis Diagnostics, amounted to 9,882, including positive results for NTM in 69 samples, which accounted for 0,7% of all tests performed. During the announcement of the pandemic in 2020, the number of tests ordered was 7,120, and a positive result was obtained from 39 samples, which was 0,54 %. The number of ordered tests in the first year of the pandemic decreased by nearly 30%. In the case of molecular tests, the number of tests performed in 2020 decreased by 14% compared to 2018 (3,326 and 2,869 tests, respectively). The drastic decrease in research was also visible in relation to specific months in which successive ‘waves’ of infections and peaks of COVID-19 cases occurred. Research was often reduced by as much as 60% during these periods. The COVID-19 pandemic has significantly affected the number of mycobacterial diagnoses. The decrease in ordered tests was related to changes in the organization of medical facilities, the transformation of departments or entire hospitals into single-name infectious disease hospitals, and the abandonment of diagnostics for other diseases, including mycobacteriosis.
The proper diagnosis and detection of infections caused by NTM, as well as accurate species identification and drug susceptibility profiling, hold immense significance in guiding appropriate treatment strategies. This aspect becomes particularly crucial in the case of managing infections caused by MAB complex, because of their high level of resistance. A high level of resistance limits the treatment of MABC infections to most available anti-mycobacterial drugs. Therefore, precise and timely identification of the causative species and their drug resistance profile is paramount for optimizing treatment outcomes in patients affected by MABC infections. Compared to other non-tuberculous mycobacterial NTM infections, MAB complex infections tend to have relatively poorer treatment outcomes, with an in-hospital mortality rate of up to 16% (Choi et al. 2017). In particular, MABC is associated with intrinsic and acquired resistance to most anti-mycobacterial agents, including macrolides. Macrolide antibiotics, specifically clarithromycin and azithromycin, are the cornerstone of treatment for mycobacteriosis. These antibiotics exert their therapeutic effect by binding to the V domain of the 23S rRNA in the 50S ribosomal subunit. Macrolide resistance is induced upon exposure to these drugs by the expression of the ribosome methylase-encoding erm(41) gene (Nash et al. 2009). Apart from inducible macrolide resistance, constitutive resistance, acquired point mutations in the rrl gene may also abolish macrolide susceptibility (Wallace et al. 1996). Within the MABC complex, all three species M. abscessus subsp. abscessus, M. abscessus subs. bolletii, M. abscessus subs. massiliense may exhibit constitutive resistance to macrolides by a mutation in the rrl gene (A2058C, A2058G, A2058T, A2059C, A2059G, A2059T) encoding 23S rRNA.
Another important group of drugs is aminoglycosides. However, MABC has also developed a range of resistance mechanisms against this class of antibiotics. Hence treatment of M. abscessus infections is further complicated by resistance mechanisms such as target modification and mutations in the rrs gene, leading to resistance to aminoglycosides. Furthermore, the presence of a class A β-lactamase leads to resistance against β-lactam antibiotics (Soroka et al. 2014) and the enzymatic inactivation of tetracycline presents a hurdle in its effectiveness (Luthra et al. 2018). Mounting evidence supports the involvement of efflux pumps in antibiotic resistance in M. abscessus (Mudde et al. 2022). Efflux pumps play a significant role in drug resistance by actively removing toxic substances, including antibiotics, from the cell. This efflux mechanism prevents the intracellular accumulation of antibiotics, thereby reducing their clinical effectiveness (da Silva et al. 2011).
In our research, we assessed the resistance mechanisms of MABC to aminoglycosides and macrolides. Additionally, we compared the results of molecular analysis with their correlations to phenotypic resistance determination using microdilution methods. We obtained mostly concordant results, except for one strain, which accounted for approximately 8.33% (1 out of 12) of the discordant cases. The molecular analyze of erm(41) revealed that seven of the eight species of M. abscessus subs. abscessus strains in this study possessed thymine at position 28 in the erm(41) gene, indicating that all these M. abscessus strains were capable of inducible macrolide resistance. Among the strains of M. abscessus subs. abscessus, only one strain exhibited sensitivity to macrolides, with cytosine present at position 28 in the erm(41) gene. In this strain, no mutations were found in the rrl gene, and antimicrobial susceptibility testing (AST) results indicated susceptibility to the tested antimicrobial agents.
Among MAB complex subspecies there are significant differences in susceptibility patterns. M. abscessus subsp. massiliense carries an inactive and truncated erm(41) gene (M. massiliense appeared to be an erm(41) deletion mutant) and is sensitive to macrolides, which thus brings more success in the eradication (Nash et al. 2009) M. abscessus subs. massiliense infections are much less severe and have a higher probability of success in treating than M. abscessus subs. bolletii or M. abscessus subsp. abscessus infections. This supports the hypothesis that M. abscessus subs. massiliense is the least pathogenic among the species within the MABC and in some cases it can be eradicated even spontaneously (Rollet-Cohen et al. 2019). M. abscessus subs. bolletii has been described as a clarithromycin-resistant species corresponding to the expression of functional erm(41) in the species. M. abscessus subsp. bolletii shows induced resistance to macrolides due to the presence of the genotype erm(41)T28 gene. Therefore, in the treatment of infections caused by this species, macrolides are ineffective in the treatment. In patients infected with M. abscessus subs. bolletii also tends to decline more rapidly in lung function than M. abscessus subsp. massiliense (Jönsson et al.2007; Esther et al. 2010). Thus, the determination of the genotype erm(41) in MABC species should be carried out before the initiation of macrolide therapy. Since genetic transmission under MABC may occur through horizontal gene transfer from various species, including Pseudomonas spp. it is necessary to repeat the test before each treatment (Howard 2013).
According to the IDSA (Infectious Diseases Society of America) guidelines, the recommended approach for treating lung infections is to customize the treatment based on drug susceptibility testing of macrolides and aminoglycosides, instead of using empirical therapy. To identify macrolide resistance, a 14-day incubation and/ or sequencing of the erm gene (erm(41)) is suggested (Daley et al. 2020).
It is important to highlight that not all major anti-mycobacterial drugs presented well-established links between laboratory and clinical outcomes. Thus it is recommended to conduct baseline susceptibility testing for specific drugs for each patient with a confirmed NTM disease, following the Clinical and Laboratory Standards Institute (CLSI) guidelines. Although testing additional drugs may offer potential benefits, there is currently limited data to provide specific recommendations in this context. These guidelines align with those set forth by the Infectious Diseases Society of America (Daley et al. 2020; CLSI 2018a; 2018b).
Limited therapeutic options for MABC infections associated with natural and acquired resistance to most anti-mycobacterial drugs pose a high risk of treatment failure. Differentiation of subspecies within MABC, the simultaneous determination of genes for resistance to macrolides and aminoglycosides is crucial to undertaking the correct eradication therapy.
To conclude, high clarithromycin resistance of M. abscessus, one of the drugs in first-line treatment, determines the high need for susceptibility-based treatment. Molecular determination of resistance mechanisms to aminoglycosides and macrolides enables for fast and accurate implementation of targeted treatment that is more effective than empirical treatment and reduces the risk of therapy failure. The molecular mechanism of resistance correlates with resistance defined by MIC values interpreted according to CLSI recommendations. According to the current guidelines susceptibility testing can only be interpreted with accurate strain identification. Methods based on PCR targeting 16S rRNA gene and 16S–23S rRNA regions, assessment based on the DNA STRIP technology or matrix-assisted laser desorption ionization-time of flight used in this study allowed for correct identification to the complex level. The critical distinction among these methods lies in their discriminatory power. For example, MALDI-TOF mass spectrometry demonstrates good discriminatory power for different kinds of non-tuberculous bacteria but faces challenges in reliably distinguishing organisms within the M. abscessus complex. CMdirect test may yield ambiguous results due to its similarity M. abscessus complex with M. chelonae. However, precise determination within the MAB complex conducted in this research, was possible using molecular methods based on DNA strip technology such as GenoType NTM-DR. It can be an accurate and reliable method for identifying MABC and crucial mutations conferring resistance to aminoglycosides and macrolides.
Our report is a retrospective in vitro study without the participation of humans. The studied materials were NTM strains collected by routine laboratory practice, not for scientific purposes, and stored in glycerol tubes at –80°C as a biobank collection. All individual human data associated with strains were anonymized before the researcher accessed them. According to the guidelines of the Bioethics Committee of the Jagiellonian University Medical College, Krakow, Poland, this kind of research does not meet the criteria of a medical experiment and is not subject to ethical review.